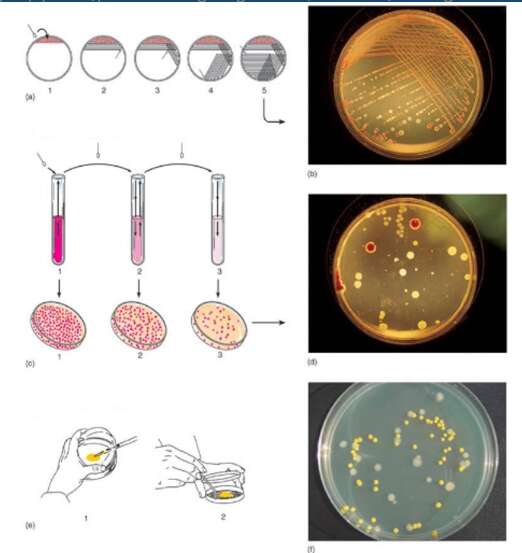

Lý thuyết Sinh học 10 Cánh diều bài 17
VnDoc xin giới thiệu bài Lý thuyết Sinh học lớp 10 bài 17: Vi sinh vật và các phương pháp nghiên cứu vi sinh vật sách Cánh diều chi tiết cùng với bài tập trắc nghiệm chọn lọc có đáp án giúp học sinh nắm vững kiến thức trọng tâm, ôn luyện để học tốt môn Sinh học 10.
Bài: Vi sinh vật và các phương pháp nghiên cứu vi sinh vật
A. Lý thuyết Sinh học 10 bài 17
I. Khái niệm vi sinh vật
Vi sinh vật là những sinh vật có kích thước nhỏ, thường được quan sát bằng kính hiển vi. phần lớn có cấu trúc đơn bào, số ít là tập đoàn đơn bào.

Vi sinh vật tồn tại ở khắp nơi trên Trái Đất và có khả năng chuyển hóa các chất dinh dưỡng nhanh nên chúng sinh trưởng và sinh sản rất nhanh.

II. Các kiểu dinh dưỡng ở vi sinh vật

Tùy vào nhu cầu sử dụng nguồn Carbon và năng lượng của vi sinh vật mà vi sinh vật được chia thành 4 kiểu dinh dưỡng như sau:

III. Một số phương pháp nghiên cứu vi sinh vật
1. Phương pháp phân lập vi sinh vật
Là phương pháp phân lập và tách riêng từng khuẩn lạc vi sinh vật cần nghiên cứu.
Khuẩn lạc vi sinh vật thường nhầy, ướt, bề mặt thường dẹt và có nhiều màu sắc ...
2. Nghiên cứu hình thái vi sinh vật bằng phương pháp quan sát bằng kính hiển vi
Phương pháp quan sát gồm 2 bước: chuẩn bị mẫu vật và quan sát bằng kính hiển vi.

3. Nghiên cứu đặc điểm hóa sinh của vi sinh vật
Phương pháp nghiên cứu đặc điểm hóa sinh của vi sinh vật gồm 2 bước: chuẩn bị mẫu và thực hiện phản ứng hóa sinh để nhận biết các chất có ở vi sinh vật.
Sơ đồ tư duy khái quát về vi sinh vật:

B. Bài tập trắc nghiệm Sinh học 10 bài 17
Câu 1: Kích thước vi sinh vật càng nhỏ thì
A. tốc độ trao đổi chất càng cao, tốc độ sinh trưởng và sinh sản càng nhanh.
B. tốc độ trao đổi chất càng cao, tốc độ sinh trưởng và sinh sản càng chậm.
C. tốc độ trao đổi chất càng thấp, tốc độ sinh trưởng và sinh sản càng nhanh.
D. tốc độ trao đổi chất càng thấp, tốc độ sinh trưởng và sinh sản càng chậm.
Hướng dẫn giải
Đáp án đúng là: A
Kích thước của vi sinh vật càng nhỏ thì tỉ lệ S/V càng lớn do đó tốc độ trao đổi chất càng cao, tốc độ sinh trưởng và sinh sản càng nhanh.
Câu 2: Đặc điểm nào sau đây của vi sinh vật đã trở thành thế mạnh mà công nghệ sinh học đang tập trung khai thác?
A. Có kích thước rất nhỏ.
B. Có khả năng gây bệnh cho nhiều loài.
C. Có khả năng sinh trưởng và sinh sản nhanh.
D. Có khả năng phân bố rộng trong tất cả các môi trường.
Hướng dẫn giải
Đáp án đúng là: C
Khả năng sinh trưởng và sinh sản nhanh của vi sinh vật là một thế mạnh mà công nghệ sinh học đang tập trung khai thác.
Câu 3: Căn cứ để phân loại các kiểu dinh dưỡng ở vi sinh vật là
A. dựa vào nguồn carbon và nguồn cung cấp vật chất.
B. dựa vào nguồn oxygen và nguồn cung cấp năng lượng.
C. dựa vào nguồn oxygen và nguồn cung cấp vật chất.
D. dựa vào nguồn carbon và nguồn cung cấp năng lượng.
Hướng dẫn giải
Đáp án đúng là: D
Dựa vào nguồn carbon và nguồn cung cấp năng lượng, vi sinh vật có 4 kiểu dinh dưỡng: quang tự dưỡng, quang tự dưỡng, hóa dị dưỡng, hóa tự dưỡng.
Câu 4: Căn cứ vào nguồn năng lượng, các kiểu dinh dưỡng ở vi sinh vật gồm
A. tự dưỡng và dị dưỡng.
B. quang dưỡng và hóa dưỡng.
C. quang dưỡng và dị dưỡng.
D. hóa dưỡng và tự dưỡng.
Hướng dẫn giải
Đáp án đúng là: B
Căn cứ vào nguồn năng lượng, các kiểu dinh dưỡng của vi sinh vật được phân loại thành quang dưỡng (sử dụng nguồn năng lượng ánh sáng) và hóa dưỡng (sử dụng nguồn năng lượng từ phản ứng hóa học).
Câu 5: Vi sinh vật sử dụng nguồn năng lượng là ánh sáng và nguồn carbon là CO2 thì sẽ có kiểu dinh dưỡng là
A. quang dị dưỡng.
B. hoá dị dưỡng.
C. quang tự dưỡng.
D. hóa tự dưỡng.
Hướng dẫn giải
Đáp án đúng là: C
Sử dụng nguồn năng lượng là ánh sáng → Kiểu dinh dưỡng là quang dưỡng. Sử dụng carbon là CO2 → Kiểu dinh dưỡng là tự dưỡng. Do đó, vi sinh vật sử dụng nguồn năng lượng là ánh sáng và nguồn carbon là CO2 thì sẽ có kiểu dinh dưỡng là quang tự dưỡng.
Câu 6: Vi sinh vật thuộc những giới nào trong hệ thống phân loại 5 giới?
A. Giới Khởi sinh, giới Nấm, giới Thực vật.
B. Giới Khởi sinh, giới Nguyên sinh, giới Nấm.
C. Giới Nấm, giới Thực vật, giới Động vật.
D. Giới Khởi sinh, Giới Thực vật, giới Động vật.
Hướng dẫn giải
Đáp án đúng là: B
Vi sinh vật gồm có các nhóm: vi khuẩn và vi sinh vật cổ (giới Khởi sinh), tảo đơn bào và nguyên sinh động vật (giới Nguyên sinh), vi nấm (giới Nấm).
Câu 7: Cho các sinh vật sau: vi khuẩn lactic, nấm men, trùng roi, trùng giày, tảo silic, cây rêu, giun đất. Số vi sinh vật trong các sinh vật trên là
A. 4.
B. 5.
C. 6.
D. 7.
Hướng dẫn giải
Đáp án đúng là: B
Các vi sinh vật trong các sinh vật là: Vi khuẩn lactic, nấm men, trùng roi, trùng giày, tảo silic.
Câu 8: Cho các đặc điểm sau:
(1) Có kích thước nhỏ bé, thường không nhìn thấy bằng mắt thường.
(2) Có khả năng phân bố rộng trong tất cả các môi trường.
(3) Có khả năng hấp thu và chuyển hóa vật chất nhanh.
(4) Có khả năng sinh trưởng và sinh sản nhanh.
Số đặc điểm chung của vi sinh vật là
A. 1.
B. 2.
C. 3.
D. 4.
Hướng dẫn giải
Đáp án đúng là: D
Vi sinh vật có một số đặc điểm chung là: kích thước nhỏ bé, số lượng nhiều, phân bố rộng, hấp thu và chuyển hoá vật chất nhanh, sinh trưởng và sinh sản nhanh.
Câu 9: Vi sinh vật có thể phân bố trong các loại môi trường là
A. môi trường đất, môi trường nước.
B. môi trường trên cạn, môi trường sinh vật.
C. môi trường đất, môi trường nước, môi trường trên cạn.
D. môi trường đất, môi trường nước, môi trường trên cạn, môi trường sinh vật.
Hướng dẫn giải
Đáp án đúng là: D
Vi sinh vật có khả năng phân bố trong tất cả các loại môi trường: môi trường đất, môi trường nước, môi trường trên cạn, môi trường sinh vật.
Câu 10: Nối nhóm vi sinh vật (cột A) với đặc điểm tương ứng (cột B) để được nội dung phù hợp.
|
Cột A |
Cột B |
|
(1) Giới Nguyên sinh (2) Giới Khởi sinh (3) Giới Nấm |
(a) Sinh vật nhân thực, đơn bào hoặc tập hợp đơn bào, dị dưỡng hoặc tự dưỡng (b) Sinh vật nhân sơ, đơn bào, dị dưỡng hoặc tự dưỡng (c) Sinh vật nhân thực, đơn bào hoặc tập hợp đơn bào, dị dưỡng |
A. 1-a, 2-b, 3-c.
B. 1-b, 2-a, 3-c.
C. 1-c, 2-a, 3-c.
D. 1-c, 2-b, 3-a.
Hướng dẫn giải
Đáp án đúng là: A
(1) – (a): Giới nguyên sinh gồm những sinh vật nhân thực, đơn bào hoặc tập hợp đơn bào, dị dưỡng hoặc tự dưỡng.
(2) – (b): Giới Khởi sinh gồm những sinh vật nhân sơ, đơn bào, dị dưỡng hoặc tự dưỡng.
(3) – (c): Giới Nấm gồm những sinh vật nhân thực, đơn bào hoặc tập hợp đơn bào, dị dưỡng.
Câu 11: Tảo, vi khuẩn lam có kiểu dinh dưỡng là
A. quang dị dưỡng.
B. hoá dị dưỡng.
C. quang tự dưỡng.
D. hoá tự dưỡng.
Hướng dẫn giải
Đáp án đúng là: C
Tảo, vi khuẩn lam có kiểu dinh dưỡng là quang tự dưỡng.
Câu 12: Mục đích của phương pháp phân lập là
A. tách riêng từng loại vi sinh vật từ hỗn hợp gồm nhiều vi sinh vật khác nhau.
B. tạo ra chủng vi sinh vật mới từ hỗn hợp gồm nhiều vi sinh vật khác nhau.
C. thống kê số lượng vi sinh vật từ hỗn hợp gồm nhiều vi sinh vật khác nhau.
D. nhân nhanh sinh khối vi sinh vật từ hỗn hợp gồm nhiều vi sinh vật khác nhau.
Hướng dẫn giải
Đáp án đúng là: A
Phương pháp phân lập nhằm tách riêng từng loài vi sinh vật từ hỗn hợp nhiều loài vi sinh vật bằng cách pha loãng và trải đều mẫu trên môi trường đặc.
Câu 13: Nối loại khuẩn lạc (cột A) với đặc điểm của khuẩn lạc (cột B) để được nội dung đúng.
|
Cột A |
Cột B |
|
(1) Khuẩn lạc vi khuẩn (2) Khuẩn lạc nấm men (3) Khuẩn lạc nấm mốc |
(a) nhầy ướt, bề mặt thường dẹt và có nhiều màu sắc (trắng sữa, vàng, đỏ, hồng, cam,...). (b) thường khô, tròn đều và lồi ở tâm, thường có màu trắng sữa. (c) thường lan rộng, xốp, có nhiều màu sắc khác nhau như trắng, vàng, đen, xanh,… |
A. 1-a, 2-b, 3-c.
B. 1-b, 2-c, 3-a.
C. 1-a, 2-c, 3-b.
D. 1-c, 2-b, 3-a.
Hướng dẫn giải
Đáp án đúng là: A
- Khuẩn lạc vi khuẩn thường nhầy ướt, bề mặt thường dẹt và có nhiều màu sắc (trắng sữa, vàng, đỏ, hồng, cam,...), một số khuẩn lạc đặc biệt có dạng bột mịn.
- Khuẩn lạc nấm men thường khô, tròn đều và lồi ở tâm, thường có màu trắng sữa.
- Khuẩn lạc nấm mốc thường lan rộng do tế bào nấm mốc phát triển tạo thành dạng sợi dài, xốp, có nhiều màu sắc khác nhau như trắng, vàng, đen, xanh.
Câu 14: Để nghiên cứu hình thái vi sinh vật thường phải làm tiêu bản rồi đem soi dưới kính hiển vi vì
A. vi sinh vật có kích thước nhỏ bé.
B. vi sinh vật có cấu tạo đơn giản.
C. vi sinh vật có khả năng sinh sản nhanh.
D. vi sinh vật có khả năng di chuyển nhanh.
Hướng dẫn giải
Đáp án đúng là: A
Vi sinh vật có kích thước nhỏ nên để quan sát được chúng người ta cần phải làm tiêu bản rồi quan sát chúng dưới kính hiển vi.
Câu 15: Cho các bước sau:
(1) Chuẩn bị mẫu vật
(2) Quan sát bằng kính hiển vi
(3) Thực hiện phản ứng hoá học để nhận biết các chất có ở vi sinh vật
(4) Pha loãng và trải đều mẫu trên môi trường đặc
Các bước trong phương pháp nghiên cứu đặc điểm hoá sinh của vi sinh vật là
A. (1), (2).
B. (1), (3).
C. (1), (3), (4).
D. (1), (2), (3), (4).
Hướng dẫn giải
Đáp án đúng là: B
Phương pháp nghiên cứu đặc điểm hóa sinh của vi sinh vật gồm 2 bước: chuẩn bị mẫu và thực hiện các phản ứng hóa học để nhận biết các chất có ở vi sinh vật.
>>>> Bài tiếp theo: Lý thuyết Sinh học 10 Cánh diều bài 18
Như vậy VnDoc đã giới thiệu các bạn tài liệu Lý thuyết Sinh học lớp 10 bài 17: Vi sinh vật và các phương pháp nghiên cứu vi sinh vật sách Cánh diều. Mời các bạn tham khảo thêm tài liệu: Trắc nghiệm Sinh học 10, Giải bài tập Sinh học lớp 10, Giải Vở BT Sinh Học 10, Sinh học 10 Kết nối tri thức, Sinh học 10 Chân trời sáng tạo, Tài liệu học tập lớp 10.